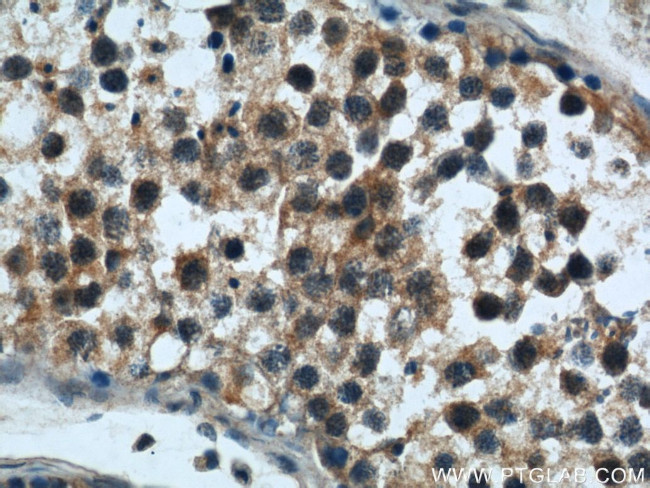
Rabenosyn 5 Antibody in Immunohistochemistry (Paraffin) (IHC (P))
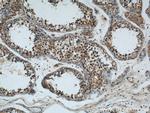
Rabenosyn 5 Antibody in Immunohistochemistry (Paraffin) (IHC (P))

Search
Proteintech
Rabenosyn 5 Polyclonal Antibody
{{$productOrderCtrl.translations['antibody.pdp.commerceCard.promotion.promotions']}}
{{$productOrderCtrl.translations['antibody.pdp.commerceCard.promotion.viewpromo']}}
{{$productOrderCtrl.translations['antibody.pdp.commerceCard.promotion.promocode']}}: {{promo.promoCode}} {{promo.promoTitle}} {{promo.promoDescription}}. {{$productOrderCtrl.translations['antibody.pdp.commerceCard.promotion.learnmore']}}
产品信息
22218-1-AP
种属反应
宿主/亚型
分类
类型
抗原
偶联物
形式
浓度
规格
纯化类型
保存液
内含物
保存条件
运输条件
产品详细信息
Immunogen sequence: LRKAEGWLP LSGGQGQSED SDPLLQQIHN ITSFIRQAKA AGRMDEVRTL QENLRQLQDE YDQQQTEKAI ELSRRQAEEE DLQREQLQML RERELERERE QFRVASLHTR TRSLDFREIG PFQLEPSREP RTHLAYALDL GSSPVPSSTA PKTPSLSSTQ PTRVWSGPPA VGQERLPQSS MPQQHEGPSL NPFDEEDLSS PMEEATTGPP AAGVSLDPSA RILKEYNPFE EEDEEEEAVA GNPFIQPDSP APNPFSEEDE HPQQRLSSPL VPGNPFEEPT CINPFEMDSD SGPEAEEPIE EELLLQQIDN IKAYIFDAKQ CGRLDEVEVL TENLRELKHT LAKQKGGTD (437-784 aa encoded by BC106940)
靶标信息
This gene encodes a zinc finger transcription factor. The encoded protein likely plays a role in transcriptional repression of interleukin 2. Mutations in this gene have been associated with posterior polymorphous corneal dystrophy-3 and late-onset Fuchs endothelial corneal dystrophy. Alternatively spliced transcript variants encoding different isoforms have been described.
仅用于科研。不用于诊断过程。未经明确授权不得转售。
生物信息学
蛋白别名: 110 kDa protein; FLJ34993; FYVE finger-containing Rab5 effector protein rabenosyn-5; MGC126210; RAB effector RBSN; Rabenosyn 5; Rabenosyn-5; unnamed protein product; Zinc finger FYVE domain-containing protein 20; zinc finger, FYVE domain containing 20
基因别名: 5330426D11Rik; KAREVS; MFANDO; Rabenosyn-5; RBSN; ZFYVE20
UniProt ID: (Human) Q9H1K0, (Mouse) Q80Y56
Entrez Gene ID: (Human) 64145, (Mouse) 78287